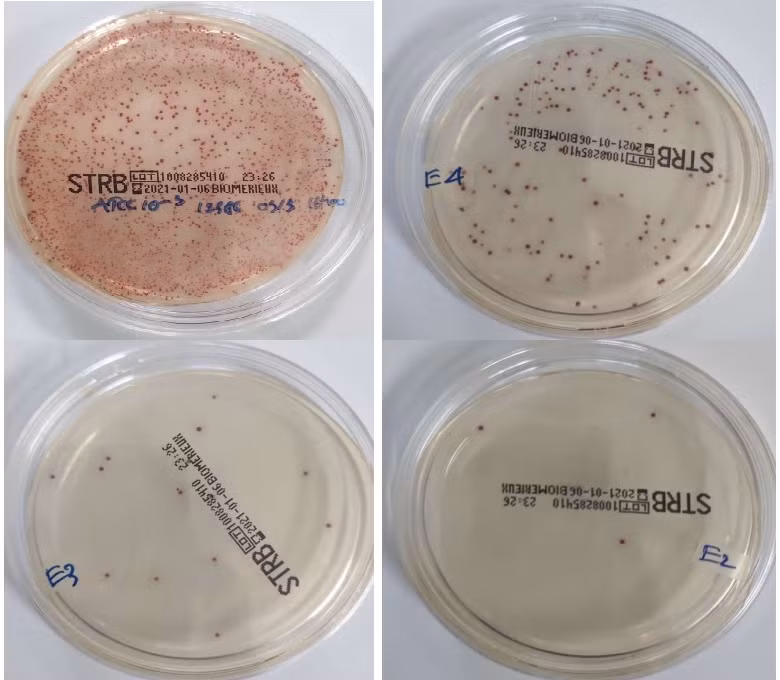
Quy trình real-time PCR cải tiến giúp phát hiện GBS nhanh, nhạy và đặc hiệu được hoàn thiện.

Quy trình real-time PCR cải tiến giúp phát hiện liên cầu khuẩn nhóm B (GBS) nhanh, nhạy và đặc hiệu được hoàn thiện từ giai đoạn tách chiết axit nucleic đến thực hiện phản ứng, phân tích kết quả.
Phát hiện sớm để tránh lây sang thai nhi
TS Hà Mạnh Tuấn, Đại học Y Dược TPHCM cho biết, liên cầu khuẩn nhóm B (Streptococcus agalactiae hay GBS) là vi khuẩn gram dương. Nhiễm vi khuẩn GBS có tính chất nhất thời, có nghĩa là bệnh nhân có thể ở tình trạng nhiễm không liên tục. Tuy nhiên, GBS là tác nhân gây nhiễm khuẩn hàng đầu và là nguyên nhân chính gây ra bệnh tật, tử vong ở trẻ sơ sinh.
Nhiễm GBS giai đoạn sớm gây ra viêm phổi, nhiễm trùng huyết và viêm màng não. Sự lây truyền từ mẹ sang con có thể xảy ra khi thai phụ có nhiễm GBS ở âm đạo, trực tràng vào thời điểm chuyển dạ hoặc vỡ ối là yếu tố nguy cơ cao và quan trọng đối với nhiễm trùng sơ sinh sớm.
Trên thế giới ước tính mỗi năm có khoảng 150.000 trẻ chết non và chết ở giai đoạn sơ sinh do GBS. GBS gây ra bệnh lý nhiễm trùng sơ sinh sớm (7 ngày tuổi) và có tới 3,5 triệu ca sinh non có thể là do GBS.
Khoảng 20 - 40% người trưởng thành mang vi khuẩn này. Việc phát hiện nhanh và chính xác về sự xâm nhiễm GBS ở thai phụ sẽ hữu ích trong việc ngăn chặn nhiễm GBS hiệu quả hơn và giảm được các gánh nặng bệnh tật do GBS gây ra.
Nhóm nghiên cứu do TS Hà Mạnh Tuấn đứng đầu đã thực hiện đề tài chẩn đoán của quy trình real-time PCR cải tiến phát hiện nhanh Streptococcus nhóm B ở thai phụ đủ tháng tại Cơ sở 2, Bệnh viện Đại học Y Dược TPHCM.
Nhóm nghiên cứu xác định tính giá trị (độ nhạy/độ đặc hiệu kỹ thuật, âm tính giả, dương tính giả) của quy trình real-time PCR cải tiến phát hiện nhanh GBS ở thai phụ đủ tháng; xác định các giá trị chẩn đoán của phương pháp real-time PCR cải tiến phát hiện nhanh GBS so với phương pháp nuôi cấy truyền thống và so với kit thương mại với cùng nguyên lý.
Trong thời gian từ tháng 4/2021 - 2/2022 tại Bệnh viện Đại học Y Dược TPHCM, 259 mẫu phết âm đạo - trực tràng đã được thu thập để xác định các giá trị chẩn đoán lâm sàng của quy trình real-time PCR tối ưu trong nghiên cứu. Qua đó nhóm đã tối ưu hóa thành công quy trình real-time PCR cải tiến, phát hiện GBS nhanh, nhạy và đặc hiệu.
Theo TS Hà Mạnh Tuấn, quy trình real-time PCR cải tiến giúp phát hiện GBS nhanh, nhạy và đặc hiệu được hoàn thiện từ giai đoạn tách chiết axit nucleic đến thực hiện phản ứng, phân tích kết quả.
Nhiều cải tiến so với kit thương mại
Theo TS Hà Mạnh Tuấn, các giá trị chẩn đoán lâm sàng của quy trình real-time PCR cải tiến đã được so sánh với phương pháp nuôi cấy (tiêu chuẩn vàng) và với kit thương mại với cùng nguyên lý.
So với phương pháp nuôi cấy, quy trình real-time PCR cải tiến có giá trị độ nhạy, độ đặc hiệu, giá trị chẩn đoán dương tính, giá trị chẩn đoán âm tính và độ chính xác lần lượt là 93,84; 97,93; 94,48; 97,72 và 96,83.
So với quy trình thương mại, quy trình real-time PCR cải tiến có giá trị độ nhạy, độ đặc hiệu, giá trị chẩn đoán dương tính, giá trị chẩn đoán âm tính và độ chính xác lần lượt là 87,80; 93,84; 84,32; 95,32 và 92,18.
Chi phí hóa chất cho một xét nghiệm real-time PCR phát hiện GBS bằng kit thương mại (Sacace) là 230.000 đồng/test, chưa kể chi phí hóa chất tách chiết. Trong khi chi phí hóa chất cho một xét nghiệm GBS trong nghiên cứu này vào khoảng 150.000 - 180.000 đồng/test.
Do đó, kết quả đề tài có thể áp dụng vào thực hành lâm sàng để phục vụ cho người dân với tiêu chí nhanh, chính xác khi phát hiện GBS với chi phí phù hợp. Điều này đáp ứng được nhu cầu trong sàng lọc GBS khi thai phụ vào chuyển dạ.
Đồng thời hướng tới nghiên cứu xa hơn về tỷ lệ phân bố các kiểu huyết thanh GBS khác nhau, phục vụ cho mục tiêu nghiên cứu dịch tễ học lâm sàng vi khuẩn GBS và làm cơ sở cho việc sử dụng vắc-xin sau này.
Tại Việt Nam, một số bệnh viện phụ sản lớn như Bệnh viện Từ Dũ, Bệnh viện Hùng Vương (TPHCM), Bệnh viện Quốc tế Phương Châu, Bệnh viện Phụ sản TP Cần Thơ đã áp dụng tầm soát Streptococcus nhóm B ở tuần thứ 35 - 37 ở các phụ nữ mang thai và sử dụng phác đồ điều trị tùy theo quy trình và phác đồ điều trị của từng bệnh viện dựa theo hướng dẫn của CDC.
Thành công của nghiên cứu có thể đưa vào ứng dụng ngay đem lại nhiều lợi ích cho người bệnh.